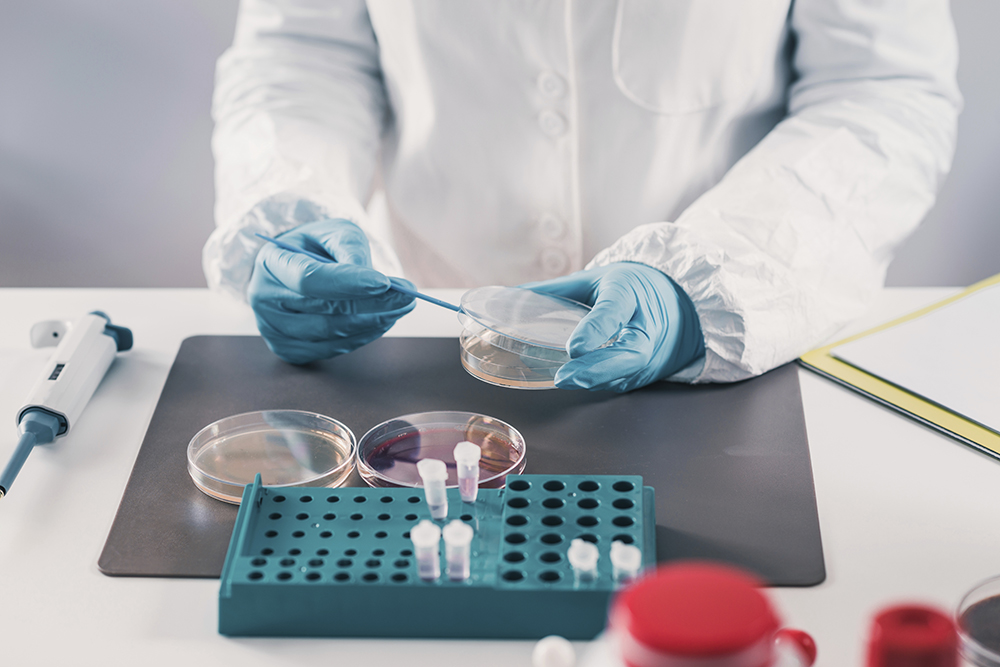

비전 및 발전목표
KFRI 소개비전 및 발전목표
비 전
국민행복과 국가산업발전에 기여하는 일류 글로벌 식품연구기관경영목표
선도적 융∙복합 연구로 글로벌 핵심기술 확보

기술산업화 역량 강화를 통한 식품산업 성장 지원

소통과 신뢰로 상생하는 조직문화 구현
추진전략
- 우수연구자 확보 및선의의 경쟁 환경 조성
- 최첨단 융·복합 신기술의경쟁우위 확보
- 국가핵심선도기술 및 미래 유망산업기술의 연구 경쟁력 강화
- 국민건강, 안전 및사회적 이슈 적극 대응
- 국제화에 의한 세계 일류연구시스템 도입 및 확립
- 산·학·연·관 공동으로 식품 산업의 新성장동력 경쟁력 제고
- 연구부문 전략목표
식품산업경쟁력 강화를 위한 원천 기술 개발
식품산업 난제 해결을 위한 기술 개발
식품산업 기반기술 고도화 연구
신시장 창출을 위한 핵심 기술 개발식품의 품질 및 소비·안전 관리시스템 개발식품 위해인자 관리 기술 개발
식품 품질속성 지능정보 기반 유통 시스템 기술 개발건강수명 증진을 위한 식품바이오 소재 및 영양대사 조절 연구초고령 시대 대응 식품의 기능 연구
맞춤형 식이모델 및 장내미생물 기반 헬스케어 연구
건강 개선 기능성 소재 개발 - 연구부문 지원부문 영역
임무중심형 연구환경 조성
우수인력 양성 전략
연구몰입 환경 조성효율적 기관 운영기관운영의 투명성 및 효율성
연구윤리 및 청렴성
연구보안성과관리·활용·확산성과관리·활용·확산체계
창업·중소벤처 지원체계
대외협력 및 소통체계

